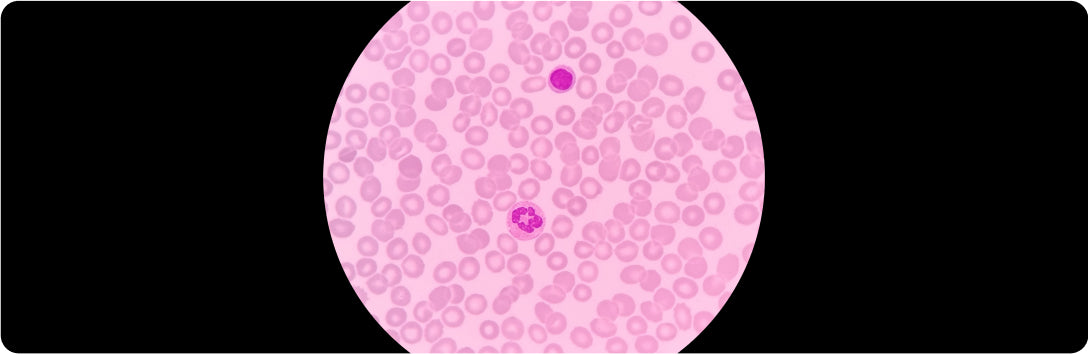

Collection:
Antibodies
Our extensive antibody collection includes monoclonal and polyclonal antibodies from human and animal sources. Choose from a variety of purifications and labels to suit your specific research needs. Whether you're conducting Western Blots, ELISAs, or immunohistochemistry, our high-quality antibodies deliver reliable and consistent results.
-
*Anti Mouse C1 Inhibitor Clone 7D10
SKU: IMSAC1INC7D10100UGRegular price From $537.00Sale price From $537.00 Regular priceUnit price / per -
*Goat Anti Mouse IgG Polyclonal Affinity Purified Immunoadsorbed HRP Labeled
SKU: IGTAMSIGGAPIAHRP10ULRegular price From $81.00Sale price From $81.00 Regular priceUnit price / per -
*Goat Anti Rabbit IgG Polyclonal Affinity Purified Immunoadsorbed HRP Labeled
SKU: IGTARBIGGAPIAHRP10ULRegular price From $81.00Sale price From $81.00 Regular priceUnit price / per -
*Goat Anti Rabbit PAI-1 Polyclonal Affinity Purified
SKU: IGTARBPAI1AP100UGRegular price From $673.00Sale price From $673.00 Regular priceUnit price / per -
*Goat Anti Rabbit PAI-1 Polyclonal Antiserum
SKU: IGTARBPAI1ASER100ULRegular price From $302.00Sale price From $302.00 Regular priceUnit price / per -
*Goat Anti Rabbit PAI-1 Polyclonal Fractionated
SKU: IGTARBPAI1GF100UGRegular price From $302.00Sale price From $302.00 Regular priceUnit price / per -
*Goat Anti Rabbit PAI-1 Polyclonal Fractionated Biotin Labeled
SKU: IGTARBPAI1GTBC 100UGRegular price From $355.00Sale price From $355.00 Regular priceUnit price / per -
*Goat Anti Rabbit PAI-1 Polyclonal Fractionated FITC Labeled
SKU: IGTARBPAI1GFFITC100UGRegular price From $355.00Sale price From $355.00 Regular priceUnit price / per -
*Goat Anti Rabbit PAI-1 Polyclonal Fractionated HRP Labeled
SKU: IGTARBPAI1GFHRP100UGRegular price From $356.00Sale price From $356.00 Regular priceUnit price / per -
*Innovative Grade US Origin Mouse Anti Mouse Inhibitory Prekallikrein Monoclonal Clone 14E3
SKU: IMSAMSIPK14E3C100UGRegular price From $323.00Sale price From $323.00 Regular priceUnit price / per -
*Innovative Grade US Origin Sheep Anti Human tPA Polyclonal IgG Fractionated Biotin Labeled
SKU: ISHAHUTPAIGGBL1MGRegular price From $323.00Sale price From $323.00 Regular priceUnit price / per -
*Mouse Anti Bovine Serum Albumin (BSA) Monoclonal Clone 12C8D4
SKU: IMSABOALB12C8D4C1MGRegular price From $254.00Sale price From $254.00 Regular priceUnit price / per -
*Mouse Anti Bovine Serum Albumin (BSA) Monoclonal Clone 9E2C2
SKU: IMSABOALB9E2C2C1MGRegular price From $254.00Sale price From $254.00 Regular priceUnit price / per -
*Mouse Anti Human 515 kDa LRP Monoclonal Clone 8G1
SKU: IMSAHU515LRP8G1C1MGRegular price From $554.00Sale price From $554.00 Regular priceUnit price / per$523.00 -
*Mouse Anti Human 515 kDa LRP Monoclonal Clone 8G1 Biotin Labeled
SKU: IMSAHU515LRP8G1CBL100UGRegular price From $254.00Sale price From $254.00 Regular priceUnit price / per
The latest in science and research
-
Product References
Breakthrough ELISA & CLIA Kits from Innovative Research
By Adam Awdish On Aug 16, 2024At Innovative Research, we're committed to providing cutting-edge tools that empower your scientific discoveries. Our premium selection of human immunoassay...
-
Product References
In Stock Alert: Human and Animal-sourced tPA
By Wendy Wise On Jun 05, 2024Understanding Human Tissue Plasminogen Activator (tPA) tPA is an essential enzyme in the body that helps break down blood clots...
-
Product References
Trending ELISA Kits, Designed with You in Mind - Order Now While Supplies Last
By Adam Awdish On May 22, 2024We currently have overstock of some of our current most popular ELISA Kits, including coagulation factor kits, IgG, tPA, and...
Explore other categories
1
/
of
7